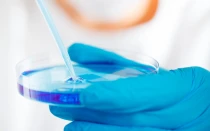

Iglesia en Colombia
Últimas noticias
[VIDEO] Colombianos rezan Rosario en sitios donde ocurren homicidios para combatir violencia
El Arzobispo de Cali (Colombia) Mons. Darío de Jesús Monsalve Mejía, preocupado por el índice de homicidios en la ciudad,... Leer más
Suspenden temporalmente exposición de arte blasfemo en Colombia
El ministerio de Cultura de Colombia suspendió la exposición de arte blasfemo “Mujeres Ocultas”, luego de que así lo exigiera... Leer más
Miles piden a autoridades colombianas suspender exposición de arte blasfemo
Miles de personas en Colombia exigen al Ministerio de Cultura que se suspenda la exposición de arte blasfemo titulada “Mujeres... Leer más
El Papa Francisco nombra un Obispo para Colombia
El Papa Francisco nombró como nuevo Obispo de Santa Marta (Colombia) a Mons. Luis Adriano Piedrahita Sandoval, quien se desempeñaba... Leer más
Mons. Castro pide que no se paralicen los esfuerzos para lograr la paz en Colombia
El Presidente de la Conferencia Episcopal de Colombia (CEC), Mons. Luis Augusto Castro, hizo un llamado para que no se... Leer más
Colombia: Iglesia rechaza proyecto para legalizar uso médico de marihuana
El exsecretario de la Conferencia Episcopal de Colombia (CEC), Mons. Juan Vicente Córdoba, rechazó que se quiera legalizar el uso... Leer más
Cardenal Salazar: Solo la valentía de aceptar la verdad traerá la paz a Colombia
El Arzobispo de Bogotá (Colombia), Cardenal Rubén Salazar Gómez, llamó a la población a trabajar por una patria más justa,... Leer más
¿Por qué es grave profanar una tumba?
En diversos lugares personas como brujos o chamanes, y en algunos casos hasta estudiantes de medicina negocian con huesos humanos,... Leer más
Vaticano y CELAM organizan seminario de comunicaciones para Obispos de la región Bolivariana
El Pontificio Consejo para las Comunicaciones Sociales (PCCS) y el Consejo Episcopal Latinoamericano (CELAM) anunciaron la realización en Bogotá (Colombia)... Leer más
Iglesia en Colombia: No podemos quedarnos con una reconciliación “falsa o barata”
El nuevo Presidente de la Conferencia Episcopal de Colombia (CEC), Mons. Luis Augusto Castro, resaltó que la Iglesia ha trabajado... Leer más
Mons. Luis Augusto Castro es el nuevo Presidente de la Conferencia Episcopal de Colombia
Los obispos reunidos en asamblea plenaria eligieron como nuevo Presidente de la Conferencia Episcopal de Colombia (CEC) a Mons. Luis... Leer más
Hoy Colombia celebra a su Patrona: La Virgen de Chiquinquirá
Cada 9 de julio se celebra la advocación mariana de Nuestra Señora del Rosario de Chiquinquirá, que fue proclamada por... Leer más
Nuncio pide reforzar “la reconciliación sacramental” por el bien de Colombia
El Nuncio Apostólico en Colombia, Mons. Ettore Balestrero, dijo que se necesita reforzar la reconciliación sacramental no solo para la... Leer más
El Papa nombra Nuncio Apostólico para Costa Rica y Obispo auxiliar para Colombia
El Papa Francisco nombró hoy como Nuncio Apostólico en Costa Rica a Mons. Antonio Arcari, quien se desempeñaba hasta hoy... Leer más
No hay evangelización fuerte si la familia no vive su verdad más profunda, dice Obispo colombiano
El Presidente de la Comisión Episcopal de Familia en Colombia, Mons. Pablo Emiro Salas Anteliz, señaló que “no podrá haber... Leer más
Nuncio en Colombia pide rezar por el Papa Francisco y colaborar con sus obras de caridad
Mons. Ettore Balestrero, Nuncio Apostólico en Colombia, invitó a todos los fieles católicos a participar de tres celebraciones en las... Leer más
Estado no puede permitir que se “fabriquen” seres humanos en Colombia, dice vocero del Episcopado
El P. Pedro Mercado, Secretario Adjunto de la Conferencia Episcopal de Colombia (CEC) y encargado de las relaciones con el... Leer más
Día Mundial del Refugiado: Iglesia debe ayudar a que “abramos el corazón” a ellos
En el marco del Día Mundial del Refugiado que se celebra este 20 de junio, el Nuncio Apostólico en Colombia... Leer más
Colombia: Arzobispo espera que tras reelección Juan Manuel Santos trabaje por la paz
El Arzobispo de Villavicencio (Colombia), Oscar Urbina Ortega, explicó desde Roma que el presidente reelegido el domingo por los colombianos,... Leer más
Obispo pide orar para que Dios muestre el camino a Colombia ante segunda vuelta presidencial
"Votemos en conciencia y dejemos que Dios nos muestre el camino", expresó el Secretario General de la Conferencia Episcopal Colombiana... Leer más